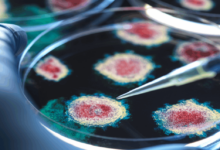

أرقام مخيفة… السكتة الدماغية تطال الاصغر سنا

وتخصص الولايات المتحدة، شهر مايو، سنويا للتوعية بالسكتة الدماغية، وتعد هذه المناسبة أيضا وفق شبكة أخبار “فوكس نيوز” الأميركية، فرصة ليبحث الأطباء عن إجابات عن سبب حدوث السكتات الدماغية لدى المرضى الأصغر سنا.
ونقلت الشبكة عن الشاب دانيال جينر، الذي أصيب بجلطة دماغية في سن 29 عاما، قوله: “كانت هذه أول مشكلة صحية حقيقية أواجهها”، بينما قالت زوجته إن ذلك حدث بشكل غير متوقع.
وكشفت أن الأمر بدا وكأنه صداع شديد في رأسه، ثم تبين أن ذلك كان جلطة دماغية، أحدثت نزيفا في المخ.
وذكر جينر أن الأطباء قالوا له إن فرص بقائه على قيد الحياة كانت ضئيلة.
الأسباب
ويعمد باحثون إلى تقفي أسباب ارتفاع نسب الإصابات لدى من تقل أعمارهم عن 60 أو 50 عاما، وانكب كثيرون على البحث في تغير أنماط الحياة الحديثة مقارنة بالسابق، وكل ما يتعلق بطريقة العمل والأكل والسفر وضغوطات الحياة عموما.
وبما أن مواطني الدول العربية يعيشون نفس أنماط الحياة التي يعيشها الغرب بسبب ظروف العولمة، أصبحوا معرضين هم أيضا للإصابة بهذه الأنواع من الأمراض، وفق ما قاله رئيس جمعية الصحة العامة الأردنية، الدكتور بسام حجاوي.
وكشف حجاوي في حديث لموقع “الحرة” أن الأمراض التي كانت الأكثر شيوعا في الشرق الأوسط وشمال أفريقيا تدخل ضمن قسم الأمراض المعدية، لكن السنوات الأخيرة تشهد تغيرا تدريجيا لتزداد الأمراض المرتبطة بأنماط الحياة وضغوط الحياة المعاصرة لدى سكان الدول العربية، على حد تعبيره.
ولفت حجاوي إلى أن الوعي بخطورة ذلك، لم يصل إلى المستوى المطلوب وهو ما يفسر استمرار المنحنى التصاعدي لأمراض غير معدية، وعلى رأسها الجلطات الدماغية.
والسكتة الدماغية هي حالة طارئة يتسبب بها انقطاع الدم عن المخ أو جزء منه، ثم ينقطع الأوكسجين عن أنسجة المخ من الغلوكوز خصوصا، وفي غضون دقائق تبدأ خلايا الدماغ المحرومة بالموت مسببة جلطة.
يذكر أنه إذا ما لم يتم اكتشاف السكتة في وقت مبكر يمكنها أن تتسبب بتلف دائم في الدماغ، أو حتى الوفاة.
أرقام مخيفة
وكان مسح أجراه المركز الوطني الأميركي للتكنولوجيا الحيوية، عام 2019، حول خصائص السكتة الدماغية في الشرق الأوسط وشمال أفريقيا توصل إلى أن معدل الإصابة لجميع السكتات الدماغية يتراوح بين 22.7 و 250 لكل 100 ألف نسمة في السنة.
“هذا معدل آخذ في الارتفاع” يقول حجاوي، الذي أصر على أن معظم العرب الذين أصيبوا بعد جائحة كورونا يعتقدون أن ذلك حدث بسبب تلقيهم جرعات من اللقاحات المضادة للفيروس التاجي الذي قتل الملايين عبر العالم في مدة أقل من ثلاث سنوات.
وقال: “الجميع يعتقد بأن لقاحات كورونا رفعت من فرص الإصابات بالسكتة الدماغية، لكن ذلك لم يثبت علميا، وأنا أرى أن نمط الحياة هو السبب الأول”.
وكان المسح ذاته قد أكد أن ارتفاع ضغط الدم يعد من أكثر أسباب الإصابة بالسكتة الدماغية المبلغ عنها في دول الشرق الأوسط وشمال أفريقيا، يليه مرض السكري.
وكان المعدل الإجمالي للوفيات في غضون شهر واحد من الإصابة بسكتة دماغية 12 بين و32 في المئة، في دول المنطقة.
هذا المسح توصل إلى نتيجة مفادها أن الذين أصيبوا بالسكتة الدماغية في الشرق الأوسط وشمال أفريقيا أصغر سنا، ولديهم معدل انتشار أعلى لمرض السكري وسكتات إقفارية أكثر شدة قليلا، وعادة ما تكون بسبب تصلب الشرايين أو الأوعية الدموية الدقيقة.
والنوبة الإقفارية العابرة هي علامة تحذيرية على اقتراب حدوث سكتة دماغية، ويشير موقع “مايو كلينيك” إلى أنها تسمّى أيضا “سكتة دماغية مصغّرة”، وأنها تعتبر “علامة تحذيرية”.
ونوه الموقع ذاته إلى أنه “يُصاب ما يقرب من شخص واحد من كل ثلاثة أشخاص لديهم النوبة الإقفارية العابرة بسكتة دماغية بمرور الوقت، ونصفهم تقريبا يُصاب بها خلال عام من الإصابة بالنوبة الإقفارية العابرة”.
ونصح تقرير الدراسة التي اعتمدت على هذا المسح، بضرورة تحسين متابعة أولئك الذين أصيبوا بنوبات إقفارية، حيث يُشتبه في أن الانصمام القلبي والرجفان الأذيني (عدم انتظام ضربات القلب) غير المشخصين كثيرا في بلدان الشرق الأوسط وشمال أفريقيا، كانا من أهم المؤشرات للإصابة بالسكتة الدماغية.
ويعود حجاوي ليقول إن تغيير أنماط الحياة عموما قد يساعد على تلافي ارتفاع عدد الإصابات بالسكتة الدماغية وقال إن التشخيص المبكر أيضا يساعد على كبح هذا الانتشار للسكتة القلبية في الدول العربية.
وذكر أن التدخين، من بين أسباب الإصابة بالسكتة الدماغية في البلدان العربية، كما رجح أن يكون ضغط الدم ومرض السكري من الأسباب الرئيسة للإصابة بالسكتات الدماغية في المنطقة، لكنه نوه أيضا إلى أن الضغوط النفسية لها دور.
وينصح حجاوي بضرورة التكفل بأولئك المصابين بالسكري وضغط الدم على وجه التحديد، لأنهم مرشحون أكثر من غيرهم للتعرض لسكتة قلبية “حتى لو كانوا شبابا” وفق تعبيره.
وعاد حجاوي للتأكيد على أن التبغ بمختلف أنواعه، والمنتشر كثيرا في الشرق الأوسط وشمال أفريقيا، يعد سببا لا يمكن إغفاله، مؤكدا أن السجائر الإلكترونية هي أيضا من مسببات السكتة الدماغية، على عكس ما يعتقد البعض.
ويميل الشباب إلى السجائر الإلكترونية “الفيب” للتوقف عن تدخين السجائر العادية، التي أثبتت دراسات أنها مضرة هي الأخرى بطرق مختلفة.
ومن بين الأضرار “إمكانية الإصابة بالسكتة الدماغية” وفق حجاوي.
علامات الإصابة
غالبا ما تظهر علامات السكتة الدماغية فجأة، لكن حجاوي يرى بأن هذا لا يعني أنه لن يكون لديك وقت للتصرف.
ويعاني بعض الأشخاص من أعراض مثل الصداع أو التنميل أو الوخز قبل عدة أيام من إصابتهم بسكتة دماغية خطيرة.
ووجدت إحدى الدراسات أن 43 في المئة من مرضى السكتة الدماغية عانوا من أعراض السكتة الدماغية المصغرة (الإقفارية) لمدة تصل إلى أسبوع قبل إصابتهم بسكتة دماغية كبيرة.
وينصح الأطباء بأن المصابين بالسمنة، جراء عادات التغذية السيئة، وأولئك المصابين بالسكري وضغط الدم وأمراض العصر عموما بأن يغيروا من عادات أكلهم ويتفادوا الأطعمة التي ترفع سكر الدم وتلك التي تشجع ارتفاع الكوليستيرول في سبيل تلافي الإصابة بالسكتة الدماغية.
ويرى حجاوي في الصدد أن هذه الأمراض عموما لم تكن منتشرة بكثر لدى أجدادنا مرجعا “إصابتنا بها في عصرنا الحديث إلى تغير نمط عيشنا وكثرة تناولنا للأدوية”.
وثبت أن بعض الأدوية تساهم أيضا في رفع فرص الإصابة بالسكتة الدماغية بينها تلك التي توصف لتمييع الدم والمعروفة بمضادات التخثر.
ينصح حجاوي أخيرا أن يهتم الشباب العربي أكثر بممارسة الرياضة، والتوقف عن العائدات السيئة المتعلقة بالتغذية والتدخين، والإفراط في الأكل غير الصحي.(الحرة)
مصدر الخبر
للمزيد Facebook